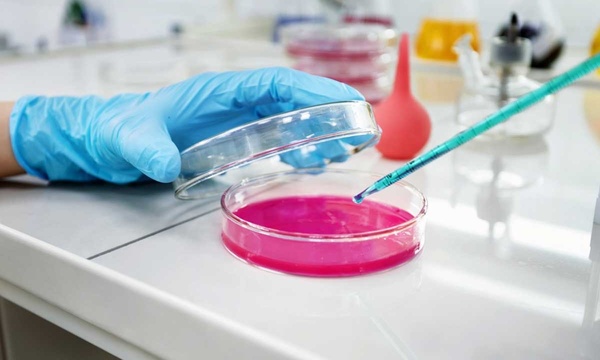
خدمات آزمایشگاهی حیوانات

دکتر خوش برخورد و صبور،بچه استرس گرفته بود با ملایمت و نوازش همراه همکار خانم خونگیری و نمونه گیری کردن و اصلا بچه اذیت نشد،
خدمات آزمایشگاهی حیوانات در تهران
دریافت قیمت از متخصص های خدمات آزمایشگاهی حیوانات
دریافت قیمت از متخصص های خدمات آزمایشگاهی حیوانات

متخصصین خدمات آزمایشگاهی حیوانات
از میان نظر ها
31 نظر۵
عالی.. ممنون از خانم دکتر. مجبور شدن راه دوری رو تشریف بیارن. . خیلی کامل راهنمایی کردن مارو.. پسرم هم حالش خیلی خوبه.... حتما ایشون رو پیشنهاد میکنم
از زحمتشون خیلی ممنونم. هم به موقع اومدن هم کار کاملا در آرامش و نهایت خوش اخلاقی انجام شد هم اینکه تا فرداش پیگیر حال گربه من بودن و راهنماییم کردن.
926 خدمت دیگر در تهران فعال است.
خدمات خدمات آزمایشگاهی حیوانات در کدام مناطق تهران ارائه میشود؟
سنجاق تمام مناطق و محلههای تهران را تحت پوشش دارد و درخواست شما را از هرجای تهران به دست متخصصها میرساند. برخی از مناطق زیر پوشش تهران:
مشاهده بیشتر









